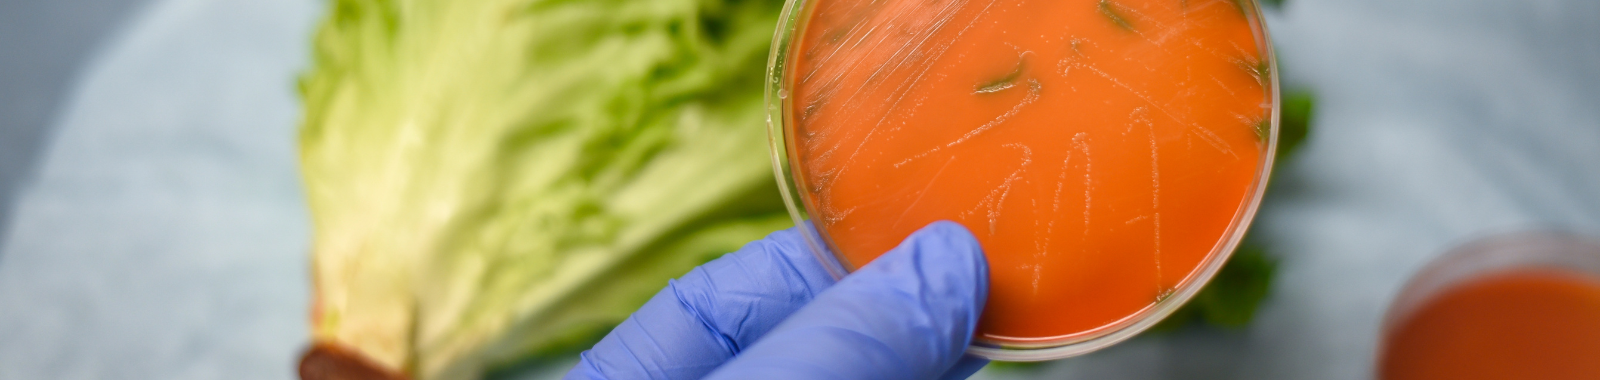

Free bite-sized webinar: Listeria and limits
Search >>
What makes Listeria monocytogenes such a big deal in food safety? What should food businesses take into consideration when setting limits for it?
Whether the topic is new to you, or you’d like a reminder, please join us for our whistle-stop tour around a bacterium with a big impact.
About Speaker
Ali Aitchison
Food Safety Specialist
Eurofins Food Testing UK & Ireland